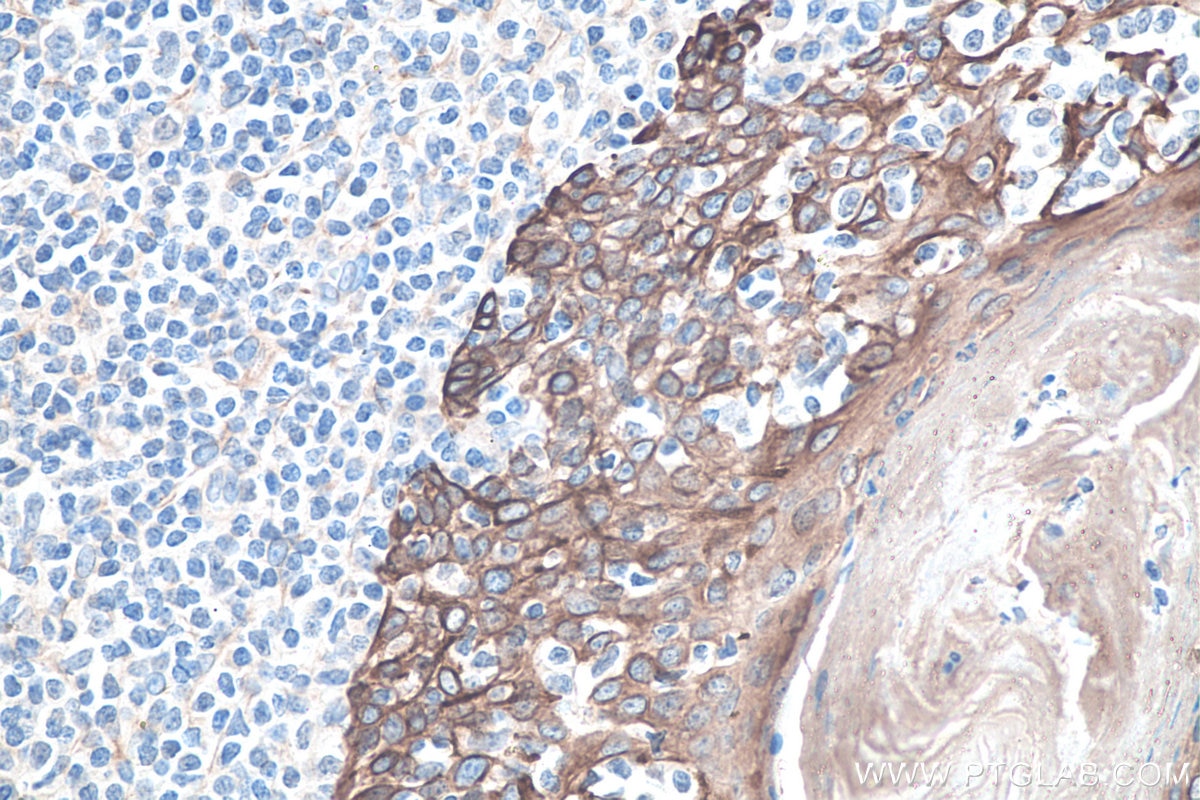
Cytokeratin 8 Antibody 10384 1 Ap Proteintech

Representative Immunohistochemical Staining For Cytokeratins 1 1 Download Scientific Diagram

Immunohistochemical Staining For Detection Of Cytokeratin Vimentin And Download Scientific Diagram

Representative Immunohistochemical Staining For Cytokeratin And Download Scientific Diagram


Understand Protein Expression In Tissue With Immunohistochemistry Ihc Cell Signaling Technology

Cytokeratin 20 Antibody 17329 1 Ap Proteintech
Pan Cytokeratin Polyclonal Antibody Bioss

Diagnostic And Prognostic Impact Of Cytokeratin 18 Expression In Human Tumors A Tissue Microarray Study On 11 952 Tumors Molecular Medicine Full Text

Anti Cytokeratin Antibody Mnf116 Ab756 Abcam

Immunohistochemical Staining Of A Patient With Hvptc A Cytokeratin Download Scientific Diagram
Cytokeratin Antibody Anti Human Hybridomas Macs Antibodies Products Miltenyi Biotec Usa
Cytokeratin 8 Antibody 10384 1 Ap Proteintech
